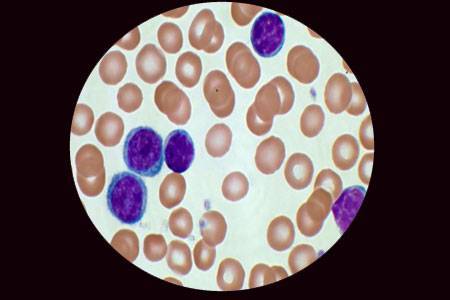
Основные методы лабораторного выявления бактерий

Мазок на микрофлору и чувствительность к антибиотикам
Бактериологический посев позволяет не только выяснить, какая микрофлора содержится в клиническом материале. Он также дает возможность определить чувствительность выделенных патогенов к антибиотикам. Зачем это нужно?
Мазок на чувствительность к антибиотикам позволяет:
- выбрать оптимальный препарат для лечения;
- оценить способность некоторых бактерий (например, золотистого стафилококка) продуцировать бета-лактамазу, которая делает его нечувствительным ко многим антибиотикам;
- подобрать дозировку антибиотика для достижения наилучшего эффекта терапии.
Мазок на посев на чувствительность антибиотикам часто используется при рецидивирующих инфекциях. Или, когда стандартные схемы терапии не принесли результата. Как правило, безрезультатность лечения, если больной соблюдал все назначения врача, обусловлена антибиотикорезистентностью. В таких случаях проводится анализ на чувствительность к антибиотикам.
Мазок позволяет определить, какие препараты и в каких дозах должны использоваться. Чувствительность к разным антибиотикам оценивается отдельно. Для каждой инфекции есть свой список антибактериальных препаратов.
Возможные результаты:
- чувствительный (S);
- малочувствительный (I);
- резистентный или нечувствительный (R).
Лучше всего лечить выявленную инфекцию антибиотиком, к которому имеется наибольшая чувствительность. Совершенно нет смысла применять препараты, к которым выделенные микроорганизмы резистентные.
Врачи подчеркивают важность мазка на флору для оценки состояния женского здоровья. Этот анализ позволяет выявить баланс микрофлоры влагалища и определить наличие воспалительных процессов. Нормальные результаты обычно включают преобладание лактобактерий, что свидетельствует о здоровой микрофлоре. Врачи используют таблицы, чтобы расшифровать результаты: степень чистоты может варьироваться от первой до четвертой. Первая степень указывает на идеальное состояние, тогда как четвертая сигнализирует о выраженном воспалении и необходимости лечения. Специалисты рекомендуют проходить этот анализ регулярно, так как он помогает предотвратить серьезные заболевания и поддерживать репродуктивное здоровье.

Расшифровка бактериологического мазка
При исследовании интерпретация результата бактериологического мазка включает:
- наличие микроорганизма в исследуемом материале – присутствует он или отсутствует;
- количество бактерий (оценивается в колониеобразующих единицах или КОЕ);
- данные антибиотикограммы (чувствительность, малочувствительность или резистентность бактерии к антибиотикам).
Для патогенных бактерий не важно количество. Например, при культуральном исследовании на гонококк сам факт обнаружения этой бактерии является основанием для установления диагноза и назначения лечения
Другие микроорганизмы являются условно-патогенными. Они провоцируют воспалительные процессы, только если присутствуют в чрезмерно больших концентрациях. Часто женщины сдают бактериологический мазок из влагалища на флору.
В биоматериале определяются условно-патогенные бактерии. Как правило, если их количество меньше 104 КОЕ, они не указываются в результатах вообще или считаются невыявленными. Если же количество превышает 104 КОЕ, такая концентрация бактерий считается клинически значимой. В этом случае результат отражается в анализе с указанием количественных характеристик.
Как подготовиться к исследованию и порядок его проведения
Для того чтобы данные, полученные в ходе микроскопического исследования, были верными, необходимо правильно подготовиться к проведению процедуры. Прежде всего следует соблюдать следующие правила:
- Воздержаться от половой близости в течение двух дней до визита к гинекологу.
- Отменить использование лубрикантов, свечей для влагалища и спринцевание за пару дней до процедуры.
- Проводить процедуру нельзя во время менструации.
- Не стоит принимать ванную за 2 дня до взятия анализа на флору.
- В день посещения гинеколога не используйте для подмывания наружных половых органов моющие средства, кроме обычного туалетного мыла.
- Постарайтесь воздержаться от мочеиспускания в течение трех часов до процедуры.
Процедуру проводит врач гинеколог на гинекологическом кресле. Во влагалище вводится специальное зеркальце, а при помощи шпателя или стерильного ватного тампона производится сбор материала для исследования. Как правило, мазок берется из трех мест – цервикального канала шейки матки, отверстия мочеиспускательного канала и слизистой влагалища. Процедура не вызывает неприятных или болезненных ощущений, не требует реабилитации или восстановления.
Мазок на флору у женщин — это важный анализ, который помогает оценить состояние микрофлоры влагалища и выявить возможные инфекции. Результаты исследования обычно представлены в виде таблицы, где указаны нормы для различных видов бактерий, таких как лактобактерии, гарднереллы и другие. Нормальные показатели свидетельствуют о здоровом состоянии, в то время как отклонения могут указывать на дисбактериоз или инфекционные заболевания.
Расшифровка результатов включает в себя анализ степени чистоты, которая делится на четыре категории. Первая степень говорит о преобладании лактобактерий и отсутствии патогенной флоры, в то время как третья и четвертая степени могут указывать на наличие воспалительных процессов и требуют дальнейшего обследования. Женщины часто обсуждают важность регулярных анализов, так как это позволяет своевременно выявлять и лечить заболевания, поддерживая здоровье репродуктивной системы.

В чем отличия между бакпосевом, мазком на флору и степень чистоты влагалища
В методе исследования. При общем мазке материал, нанесенный на стеклышко, окрашивают специальными красителями и смотрят под микроскопом. А когда делают бактериологическое (бакпосев, культуральное, микробиологическое) исследование, то его сначала «высеивают» на питательную среду. А потом, через несколько дней, смотрят под микроскопом — колонии каких микроорганизмов выросли.
То есть, если речь идет об экспресс анализе, вам дадут заключение только о количестве лейкоцитов, эпителия и слизи. Посев срочным не бывает
Также при микроскопии можно довольно быстро определить степень чистоты из влагалища. Здесь врач только оценивает соотношение между нормальной, условно-патогенной и патогенной микрофлорой.
Классическая оценка чистоты влагалища.
| I степень | Большое количество грамположительных палочек (Дедерлейна). Не много клеток плоского эпителия. |
| II степень | Присутствуют кокки в поле зрения. Но их количество не велико, в сравнении с грамположительными палочками. |
| III степень | Кокковая флора. Много лейкоцитов. |
| IV степень | Палочки Дедерлейна практически отсутствуют. Много условно-патогенных микроорганизмов. Сплошь лейкоциты. |
Обновленная таблица
| Степени | Признаки |
| I | Палочки Дедерлейна, плоский эпителий. |
| II | Негноеродные бактерии. Лейкоциты в норме. Диагноз: негнойный бактериальный кольпит. |
| III | Гноеродные (стафилококки, стрептококки, синегнойная палочка, гонококки и т. д.) микроорганизмы. Высокий уровень лейкоцитов. Гнойный бактериальный кольпит. |
| IV | Гонорея (обнаружены гонококки). |
| V | Трихомониаз (обнаружен трихомонады). |
| VI | Вагинальный кандидоз (обнаружены грибы). |
Как подготовиться к сдаче анализа и когда он необходим
Мазок врач берет у пациентки на гинекологическом кресле (независимо от того — беременна она или нет) с помощью специальной щеточки или стерильной ложечки Фолькмана. Это совсем не больно и очень быстро.
Добиться хорошего, даже идеального мазка технически можно, если санировать влагалище хлоргексидином или мирамистином, например. Но какой в этом смысл?
Чтобы получить достоверный результат мазка, за 48 часов до его сдачи нельзя:
- спринцеваться;
- заниматься сексом;
- использовать какие-либо вагинальные средства гигиены, интимные дезодоранты, а также лекарства, если они не были назначены врачом;
- делать УЗИ с использованием вагинального датчика;
- проходить кольпоскопию.
- до посещения гинеколога или лаборатории, за 3 часа, не следует мочиться.
Сдавать мазки нужно вне менструального кровотечения. Даже если есть просто «мазня» в последний день месячных, лучше отложить исследование, так как результат наверняка будет плохим — выявится большое количество лейкоцитов.
Относительно приема алкоголя запретов нет.
Можно ли сдавать мазок при приеме антибиотиков или сразу после лечения? Нежелательно это делать в течение 10 дней после использования местного действия препаратов (вагинальных) и одного месяца по прошествии приема антибактериальных средств внутрь.
Микроскопическое исследование назначают:
- в плановом порядке при посещении гинеколога;
- при поступлении в гинекологический стационар;
- перед ЭКО;
- во время беременности (особенно, если часто бывает плохим мазок);
- если есть жалобы: необычные выделения, зуд, тазовая боль и т. д.

Нормы мазка у женщин
В норме выделения присутствуют у каждой женщины, их концентрация и количество зависит от фазы менструального цикла. При появлении неприятного запаха, цвета и ощущений в области половых зуб, необходимо обратиться к врачу, для взятия анализа. Такая форма позволяет установить гормональные сбои, выявить характер выделений и назначить лечение.
В норме допускаются такие показатели:
- на видимом поле допускается до 10 клеток эпителия;
- показатель находящихся на участке лейкоцитов – до 10;
- в единичном значении должны быть составляющие промежуточного слоя;
- малое количество слизи;
- допускается наличие лактобактерий;
- количество живых микроорганизмов находится на уровне «умеренно»;
- «ложноключевые» клетки встречаются редко.
Здоровый мазок не содержит:
- эпителиальные клетки в разрушенном виде;
- эпителий с наличием бактерий на поверхности;
- аномального количества бактерицидных представителей (кроме лактобактерий);
- трихомонад;
- гонококков;
- анаэробных бактерий;
- клетки с аномалией, которые являются предвестником онкологии;
- парабазальных клеток.
Часть бактерий невозможно обнаружить методом микроскопического исследования. В этом случае назначается анализ крови. Хорошие анализы должны содержать информацию о наличие лактобактерий и лейкоцитов. Эритроциты, возбудители венерических заболеваний, а также грибковые бактерии не должны присутствовать в результатах.
О чем говорят лейкоциты в мазке на флору влагалища?
Лейкоциты – это белые клетки крови, которые призваны бороться с инфекцией. Они могут выходить сквозь стенку сосудов и передвигаться самостоятельно. Лейкоциты обладают способностью к фагоцитозу – они поглощают бактерии и переваривают их. После того, как бактерия переварена, лейкоцит разрушается. При этом освобождаются вещества, которые вызывают воспаление, проявляющееся отеком и покраснением слизистой.
В норме количество лейкоцитов во влагалище не должно превышать 10. Большое количество лейкоцитов говорит о воспалении. Чем выше число лейкоцитов, тем сильнее выражен воспалительный процесс.
Мазок у мужчин
Исследование материала из мочеиспускательных каналов у мужчин проводится с целью обнаружения скрытой инфекции. Исследование материала из уретры мужчин позволяет выявить простатит, уретрит. Однако все же чаще данный анализ у мужчин применяется для обнаружения бактерий, вызывающих венерические заболевания. Таким образом у мужчин выявляются возбудители уреаплазмоза, трихомониаза, хламидиоза, гонореи. Вместе с данными микроорганизмами обнаруживаются и лейкоциты. Однако для постановки диагноза у мужчин недостаточно результатов исследования мазка, поэтому применяется ПЦР-диагностика.
Подготовка к забору материала и проведение анализа
Гинекологический мазок – это диагностическая процедура, к выполнению которой следует подготовить организм. Мероприятия проводятся с целью предупреждения получения ложноположительных или ложноотрицательных результатов анализа.
Подготовительный этап основан на правилах «двойки»:
- За 2 недели до исследования прекращают прием лекарств из группы антибиотиков.
- За 2 дня до мазка запрещено вступать в интимную близость.
- За 2 дня до забора материала не используют вагинальные крема, суппозитории и гормональные медикаменты.
- За 2 часа до манипуляции запрещается выполнять мочеиспускание.
При соблюдении вышеуказанных правил можно быть уверенным, что точность результата повышается в 3-5 раз. Если получены неудовлетворительные показатели, тогда назначается повторный анализ. Забор биологического материала производится после стандартного гинекологического осмотра (на кресле с использованием зеркал) и визуальной оценки состояния стенок влагалища.
Процедура неинвазивная, то есть, во время нее пациентка не чувствует боли или дискомфорта. При помощи стерильного тампона или небольшой щетки (если берут мазок из уретры) гинеколог проводит по слизистой оболочке половых органов несколько раз. Полученную слизь помещают на предметное стекло, отправляют в лабораторию и изучают под микроскопом.
Что такое ПЦР-выявление ДНК микробов?
Для определение бактерий и вирусов, которых невозможно разглядеть под микроскопом, используют ПЦР, которая позволяет увидеть ДНК микробов. Сами микробы и их количество настолько малы, что только при увеличении количества ДНК можно их выявить.
ПЦР, или полимеразная цепная реакция, представляет собой размножение ДНК. ПЦР позволяет размножить количество ДНК микробной клетки для достижения необходимого количества микроорганизмов и их дифференцировки. Благодаря использованию ДНК микроба возможно установление не только его рода, но и видовой принадлежности. Метод ПЦР (ДНК-исследование) является одним из наиболее информативных диагностических методов. Благодаря ПЦР можно выявлять ДНК даже самых мелких бактерий и вирусов.
Норма показателей анализа по возрасту женщины
Гинекологический анализ мазка полученного биологического материала проводится по назначению врача в детском и подростковом возрасте. Нормы у здорового ребенка приведены в таблице.
| Оцениваемые показатели | 1-5 лет | 6-10 лет | 11-15 лет | 16-17 лет | Подростки, ведущие половую жизнь |
| Лейкоциты | 0-2 | 3-5 | 5-7 | До 10 | До 10 |
| Слизь | 1-2 | 1-2 | 1-2 | 1-2 | 1-2 |
| Эпителий | 1-3 | 4-6 | 5-6 | До 10 | До 10 |
| Флора | Кокковая + | Кокковая + | Смешанная | Палочковая | Палочковая |
Норма анализа мазка по гинекологии (расшифровку читайте ниже)
Указанные параметры соответствуют количеству видимых клеток тех или иных микроорганизмов, попадающих в поле зрения, при изучении материала под микроскопом. У женщин репродуктивного и старшего возраста нормы зависят от того, откуда была получена слизь.
| Показатели | Вагина (V) | Цервикальный канал (С) | Уретра (U) |
| Лейкоциты | 0-10 | 0-30 | 0-5 |
| Плоский эпителий | 5-10 | 5-10 | 5-10 |
| Гонококки | Отсутствуют | Отсутствуют | Отсутствуют |
| Трихомонады | Отсутствуют | Отсутствуют | Отсутствуют |
| Ключевые клетки | Отсутствуют | Отсутствуют | Отсутствуют |
| Дрожжи | Отсутствуют | Отсутствуют | Отсутствуют |
| Микрофлора | Множественные палочки Дедерлейна (грамположительные) | Отсутствует | Отсутствует |
| Слизь | Умеренное количество | Умеренное количество |
У пациенток репродуктивного и детского возраста отличается не только количественное содержание определенных клеток, но и список параметров, по которому оценивается состояние органов мочеполовой системы.
Расшифровка результатов: что считать нормой, а что — патологией в микрофлоре
Для начала предлагаем вашему вниманию таблицу, в которой отображены показатели так называемой первой степени чистоты. В ней нет упоминаний уретры (хотя материал забирается и оттуда), так как мы говорим о гинекологических заболеваниях. Воспалительный же процесс в мочеиспускательном канале лечит уролог.
| Показатель | Влагалище | Цервикальный канал |
| Лейкоциты | 0-10 в поле зрения | 0-30 в поле зрения |
| Эпителий | в зависимости от фазы мен. цикла | |
| Слизь | умеренно | |
| Трихомонады | нет | |
| Гонококки | нет | |
| Ключевые клетки | нет | |
| Кандиды | нет | |
| Микрофлора |
грамположительные палочки |
отсутствует |
Эпителий — количество эпителиальных клеток не считают, так как это не имеет диагностической ценности. Но слишком скудное количество эпителия говорит об атрофическом типе мазка — бывает у женщин в период менопаузы.
Лейкоциты — считаются в «поле зрения»:
- не более 10 — небольшое количество;
- 10-15 — умеренное количество;
- 30-50 — большое количество, женщина замечает патологические симптомы, а врач при осмотре диагностирует воспалительный процесс во влагалище и (или) на шейке матки.
Слизь (тяжи слизи) — в норме должна присутствовать, но большое ее количество бывает при воспалении. В уретре слизи быть не должно.
Палочковая флора или гр лактоморфотипы — норма, это защита влагалища от микробов.
Трихомонад, гонококков и ключевых клеток у здоровой женщины в шейке матки и во влагалище быть не должно. Кандиды в норме также отсутствуют. По крайней мере, в значимом количестве, которое выявляется при анализе на флору.
Годность мазка не большая. Но если женщина поступает в стационар, то у нее прямо там, при первичном осмотре на кресле, берут свежий.
Обычно результаты действительны 7-14 дней. Поэтому, если вам нужно его сдать перед операцией, сделайте это дня за 3 до поступления в больницу. Последним из назначенных анализов.
Нормы мазка на флору
Нормальные значения мазка на флору у женщины представлены в таблице:
| V | C | U | |
| Лейкоциты | 0-10 в поле зрения (во время беременности до 20) | 0-30 в поле зрения | 0-5 в поле зрения |
| Эпителиальные клетки | 5-10 в поле зрения | 5-10 в поле зрения | 5-10 в поле зрения |
| Слизь | умеренно | умеренно | отсутствует |
| Эритроциты | 0-3 в поле зрения | 0-3 в поле зрения | 0-3 в поле зрения |
| Гонококк | отсутствует | отсутствует | отсутствует |
| Трихомонада | отсутствует | отсутствует | отсутствует |
| Кандида | отсутствует | отсутствует | отсутствует |
| Ключевые клетки | отсутствует | отсутствует | отсутствует |
| Микрофлора | палочки Додерляйна в большом количестве | отсутствует | отсутствует |
Незначительные отклонения от указанных норм могут быть следствием неправильной подготовки к обследованию. Но существенное увеличение содержания лейкоцитарных клеток, особенно в сочетании с повышенным количеством плоского эпителия, эритроцитов и слизи, свидетельствует о наличии воспалительного процесса.
При обнаружении гонококков, трихомонад, дрожжевых грибков и гарднерелл возбудитель определен, и лечение доктор назначит сразу. Но в случаях воспалительной картины мазка и отрицательного анализа на эти инфекции, необходимо дальнейшее обследование с целью выявления возбудителя.
В зависимости от локализации воспалительного процесса рекомендованы следующие дополнительные анализы и обследования:
1. Во влагалище:
- фемофлор-скрининг (позволяет оценить бактериальный состав микрофлоры методом ПЦР);
- бактериальный посев мазка с определением чувствительности возбудителей к антибиотикам;
- мазок на скрытые инфекции (сифилис, мобилункус, уреаплазму, хламидии).
2. На шейке матки:
- мазок по Папаниколау (РАР-тест) или онкоцитология шейки матки;
- кольпоскопический осмотр шейки
3. В уретре:
- консультация уролога;
- общий анализ мочи;
- бактериальный посев мочи.
Цитологическое исследование
После 30 лет, каждая женщина находится в группе риска, так как увеличивается вероятность развития бактериальных инфекций, изменения эпителия и онкологических образований. Гинекологи советуют регулярно сдавать анализ на цитологию. Делается он путем сбора материала с шейки матки.
Расшифровка ПАП-анализа:
- NILM. В этом случае бактерии на ряду с лейкоцитами находятся в стабильной форме. Возможно появление признаков кандидоза и вагиноза. Эпителий в норме.
- LSIL. Для того, чтобы предотвратить раковые образование, назначается биопсию или кольпоскопию. Появляются признаки нарушения эпителиального слоя.
- ASC-H. Эпителий имеет большое количество нарушений. В большинстве случаев устанавливается диагноз – дисплазия шейки матки.
- ASC-US. В эпителии находятся участки неизвестного происхождения.
- AGC. Эпителий претерпевает аномальные изменения. В данном случае ставится диагноз – рак шейки матки.
- AIS. Обозначается карцинома или рак.
- HSIL. Симптоматика, предшествующая появлению рака шейки матки.
Расшифровка результатов
Мазок на микрофлору:
| Показатель | Допустимый показатель | Отклонения | ||
| Влагалище (V) | Шейка матки (С) | Уретра (U) | ||
| Лейкоциты | От 0 до 10 (при беременности допускается 20) | От 0 до 30 | От 0 до 5 | Чем выше уровень лейкоцитов, тем вероятней процесс воспаления. |
| Слизь | Умеренное количество | Не должно быть | Повышение уровня слизи говорит об инфекции | |
| Эпителий | От 5 до 10 | При высоком уровне есть вероятность развития воспаления | ||
| Гонококки | В норме везде отсутствуют | Обнаружение бактерий говорит о гонорее | ||
| Кандиды | Выявление говорит о молочнице (кандидозе) | |||
| Трихомонады | Появление бактерий говорит о трихомониазе | |||
| Ключевые клетки | Появление клеток говорит о вагинозе | |||
| Микрофлора | Наличие палочек Дедерлейна | Не должно быть |
Самостоятельно расшифровать анализы очень сложно, поэтому невозможно сразу понять хороший или плохой мазок. Для определения в систему расшифровки введены обозначения, которые выделяют влагалище, шейку матки и уретру. Степень чистоты определяют по 4 позициям.
Этот фактор способен отразить состояние влагалища и качество микрофлоры:
- Первая степень чистоты. Этот показатель является нормой, так как количество лейкоцитов остается на допустимом уровне. Эпителий и слизь в нормальном количестве. Данный результат говорит о том, что женщина полностью здорова.
- Вторая степень чистоты. Лейкоциты находятся на допустимом уровне. В микрофлоре находятся полезные бактерии и грибки. Эпителий и слизь на умеренном уровне. Данная степень является нормой, но на этом уровне микрофлора не так идеальна. Женщине следует внимательно следить за здоровьем и укреплять иммунитет.
- Третья степень чистоты. В этом случае лейкоциты намного выше нормы в исследуемом участке. В микрофлоре появляются болезнетворные бактерии, которые в дальнейшем активно размножаются и приводят к воспалениям. Количество лактобактерий стремится к 0. На этой стадии назначают лечение с последующим регулярным осмотром.
- Четвертая степень чистоты. Лейкоциты на высоком уровне, также присутствуют вредоносные бактерии. Эпителиальных тканей и слизи очень много. Данная степень говорит о активном росте воспалительных участков. Стадия считается запущенной, из-за этого требуется длительный курс препаратов для нормализации работы клеток.
Первый и второй случай являются нормой и не требуют вмешательства. Третья и четвертая предвещают образование и развитие воспалительных участков, в это время не допускается выполнение гинекологических манипуляций. Женщине назначается лечение, а затем проводится повторный анализ.
Что врачи не видят при микроскопии
Беременность
Чтобы ее определить, мазок не нужен и не важно какой результат он покажет. Необходимо сдать анализ крови на ХГЧ, пройти гинекологический осмотр у врача или сделать УЗИ матки
Можно определить хорионический гонадотропин в моче, но не в отделяемом из половых органов!
Рак матки и шейки матки. Чтобы диагностировать злокачественное перерождение эндометрия, необходим гистологический материал, причем в большом количестве. И забирают его непосредственно из матки при раздельном диагностическом выскабливании.
РШМ и другие патологии (эрозия, лейкоплакия, койлоцитоз, ВПЧ поражение, атипичные клетки и др.) ставят по результатам цитологического исследования. Данный анализ берется непосредственно с шейки матки, из зоны трансформации, по определенной методике с прокрашиванием по Папаниколау (отсюда и название анализа — ПАП-тест). Еще его называют онкоцитологией.
Не показывает такие инфекции (зппп) как:
герпес;
хламидиоз (хламидии);
микоплазмы (микоплазмоз);
уреаплазмы (уреаплазмоз);
ВИЧ.
Первые четыре инфекции диагностируются методом ПЦР. А определить наличие вируса иммунодефицита по мазку с высокой точностью невозможно. Нужно сдать анализ крови.
Общая информация
Бактериоскопия (от лат. «скопео» — смотрю) – это метод лабораторного исследования бактерий под микроскопом. Данный метод очень часто применяется врачами разных специальностей в случае подозрения на наличие у пациента инфекционного процесса и гнойно-воспалительных проявлений заболевания, помимо этого, его применяют при диспансерных обследованиях в гинекологической и акушерской практике.
При проведении микроскопического исследования в мазках можно обнаружить бактерии, грибы (при кандидозе), простейшие (при трихомониазе). Особо важным моментом при проведении исследования считается оценка морфологии, формы бактерий, а также их размеров и расположения. Не менее важным параметром также является количество (от скудного до массивного) и отношение к красителям (грамположительные и грамотрицательные клетки).
Нормальной флорой при изучении гинекологических мазков считаются грамположительные палочки, которые в процессе исследования описываются как лактоморфотипы. При бактериальном вагинозе микробная флора представлена обильной мелкой коккобациллярной грамвариабельной флорой и обусловлена снижением лактоморфотипов. Например, при гонорейной инфекции в мазке присутствуют грамотрицательные кокки бобовидной формы, которые располагаются парами внутри и внеклеточно. При других гнойно-воспалительных состояниях (неспецифических ) иногда могут обнаруживаться грамположительные кокки, грамотрицательные палочки. Помимо этого, в мазках также учитывается наличие эпителия, присутствие ключевых клеток и количество лейкоцитов.
При исследовании мокроты важное значение имеет наличие грамположительных кокков, которые располагаются в капсуле, обладают слегка вытянутой формой, расположены парами, морфологически сходные с пневмококками или представляют собой мелкие неодинаковой формы, грамотрицательные палочки, обладающие сходством с гемофилами. Также в мокроте могут выявляться грамотрицательные кокки, расположенные поодиночке, что может указывать на наличие у пациента бранхамелл
В мазках из ран преимущественно обнаруживаются грамположительные кокки. Однако, при использовании микроскопического исследования нет возможности дать заключение о названии бактерий, в связи с этим для определения рода и вида бактерий потребуется проведение бактериологического посева.
Какой биоматериал используется для исследования:
гинекологические мазки у женщин (биоматериалом является отделяемое наружных половых органов, уретры, влагалища, шейки матки, полости матки);
у мужчин исследованию подлежит соскоб из уретры, сперма, секрет предстательной железы;
биоматериалом для мазков другой локализации может являться мокрота, плевральная, перитонеальная, суставная и другие жидкости, раневое отделяемое, гной, мазки из зева, уха, отделяемое из глаз.
Какова норма мазка на микрофлору влагалища?
В микроскопии мазка на флору нормой считается:
- плоские клетки вагинального эпителия – до 10-ти в поле зрения;
- единичные лейкоциты – до 10-ти в поле зрения;
- клетки промежуточного слоя — единичные;
- «ложноключевые» клетки – редко;
- общее количество микроорганизмов «умеренное», иногда «большое»;
- слизь – в небольшом количестве;
- среди бактерий преобладают лактобактерии, другие типы микроорганизмов единичные, встречаются редко.
В мазке не должно быть:
- Разрушенных клеток эпителия в большом количестве. Это свидетельствует о лизисе клеток, что случается при аномальном росте лактобактерий.
- Ключевых клеток. Это клетки эпителия покрытые различными бактериями.
- Парабазальных клеток. Клетки нижних слоев слизистой. Их появление говорит о значительном воспалении либо атрофии слизистой.
- «Массивного» количества бактерий, кроме лактобактерий.
- Дрожжевые клетки с псевдомицелием и бластопорами (клетками-почками). Их присутствие указывает на молочницу.
- Строгих анаэробов – большинство из них относятся к возбудителям болезни.
- Гонококков – возбудителей гонореи.
- Трихомонад – возбудителей трихомониаза.
- Атипичных клеток, которые являются признаком предраковых или онкологических изменений.
Некоторые микроорганизмы (хламидии, различные вирусы) не обнаруживаются при осмотре под микроскопом из-за их маленького размера. Для их выявления необходим анализ крови на РПЦ.
Вопрос-ответ
Что пишут в мазке на флору?
Что показывает гинекологический мазок на флору Исследование позволяет выделить из биоматериала микроорганизмы, идентифицировать и определить их точное количество. Кроме того, анализируют и другие показатели, которые указывают на наличие воспалительного процесса.
Что такое C и V в мазке?
Нормальные показатели мазка взрослой здоровой женщины: Палочки Дедерлейна – их должно быть много, недостаток лактобацилл признак нарушенной микрофлоры влагалища. Зоны, из которых берут мазок, обозначаются такими буквами: U (мочеиспускательный канал), V (вагина), C (шейка матки).
Чего не должно быть в мазке у женщин?
Присутствия мицелия грибов, трихомонад, диплококков (в том числе и возбудитель гонореи), лептотрикса, мобилункуса и прочих патогенных микроорганизмов в нормальном мазке не допускается, даже в минимальном количестве. А их выявление – серьезный повод незамедлительно обратиться за лечением.
Как читать результаты мазка на флору?
Мазок на флору у женщин: норма C: плоский эпителий 5-10, лейкоциты 0-30, эритроциты 0-2, лактобациллы отсутствуют, умеренное количество слизи U: плоский эпителий 5-10, лейкоциты 0-5, эритроциты 0-2, лактобациллы отсутствуют, слизь отсутствует
Советы
СОВЕТ №1
Перед сдачей мазка на флору избегайте интимной гигиены с использованием мыла или антисептиков, а также не используйте вагинальные свечи и препараты за 24 часа до процедуры. Это поможет получить более точные результаты анализа.
СОВЕТ №2
Обязательно проконсультируйтесь с врачом о том, какие результаты анализа могут означать для вашего здоровья. Не стоит самостоятельно интерпретировать данные, так как это может привести к неправильным выводам и лишним переживаниям.
СОВЕТ №3
Регулярно проходите плановые обследования у гинеколога, чтобы контролировать состояние флоры и избежать возможных заболеваний. Это особенно важно для женщин, которые ведут активную половую жизнь или имеют предрасположенность к гинекологическим заболеваниям.
СОВЕТ №4
Обратите внимание на изменения в своем организме, такие как зуд, жжение или необычные выделения. Если вы заметили что-то подобное, не откладывайте визит к врачу, так как это может быть признаком дисбаланса флоры или инфекции.